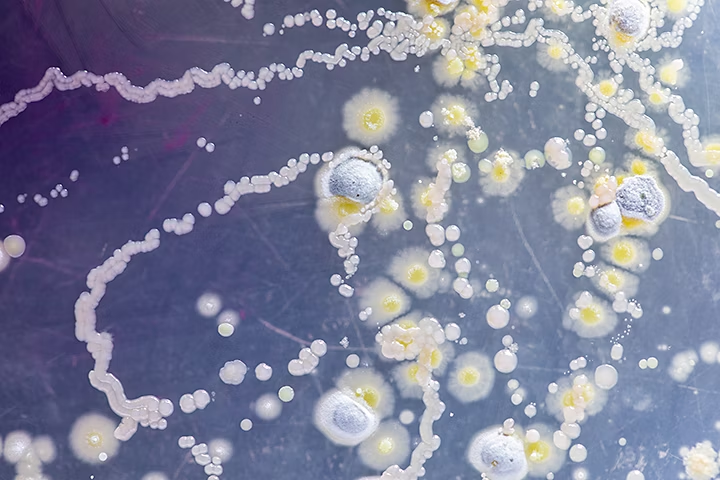

Tecniche per la fotografia astratta.
Impara a realizzare delle foto astratte sfruttando al meglio ciò che ti circonda con l’aiuto dei nostri esperti. Grazie all’imprevedibilità e ai giochi di prospettiva e di luce, potrai scattare una fotografia che, come un quadro astratto, è in grado di esaltare scene e dettagli a cui non avresti mai pensato prima.

Veduta aerea di un paesaggio come una foto astratta
Che cos’è la fotografia astratta.
La fotografia astratta consiste nell’utilizzo di attrezzature fotografiche per realizzare delle immagini che non hanno un'associazione immediata con il mondo reale.
Per creare un imprevedibile quadro astratto i fotografi usano prospettiva, proporzioni, luce e velocità dell’otturatore, trasformando così il mondo in maniera irriconoscibile.

Storia della fotografia astratta.
Le prime fotografie astratte risalgono agli anni ‘40 del XIX secolo, agli albori della fotografia. Una delle prime immagini astratte è attribuita allo scienziato statunitense John William Draper, il quale creò delle stampe che non avevano alcun riferimento alla realtà visibile grazie all’uso di uno spettroscopio.
Un importante contributo alla fotografia astratta venne dato da Anna Atkins, una botanica inglese che realizzò delle immagini negative di alghe essiccate. Questi particolari scatti dalle tonalità blu sono considerate fotografie astratte non solo per il loro colore, ma anche per l’assenza del contesto naturale delle piante.

Con la scoperta della radioattività alla fine dell’800, la fotografia astratta subì un’ulteriore accelerazione perché fu possibile creare immagini prima impossibili da realizzare. Lo scrittore August Strindberg, ad esempio, realizzò delle foto senza l’uso di un dispositivo fotografico: creò delle immagini astratte del cielo stellato utilizzando solamente delle lastre fotografiche precedentemente immerse nel liquido di sviluppo ed esposte al cielo notturno.
Nel XX secolo, con l’avvento del cubismo e del futurismo grazie a pittori e scultori del calibro di Picasso e Cézanne, la fotografia s’immerse ancora di più nell’astrazione. Grazie a importanti contributi di fotografi come Alfred Stieglitz e Paul Strand, la fotografia astratta venne riconosciuta a livello mondiale.

La fotografia astratta in Italia.
Il più grande esponente della fotografia astratta in Italia è stato Luigi Veronesi, il quale si è cimentato fin dagli anni ‘30 del XX secolo con fotogrammi e altri esperimenti caratterizzati da giochi di luce.
Grazie anche alla presenza delle avanguardie storiche, l’uso del fotogramma ha giocato un ruolo importante nel catturare immagini astratte.

10 consigli utili sulla fotografia astratta.
Non è possibile creare una guida dettagliata per la fotografia astratta; tuttavia, ci sono alcuni principi generali che vanno considerati e con cui sperimentare e praticare la propria tecnica. Ecco, quindi, dieci consigli utili per poter padroneggiare appieno la fotografia astratta:
1. Gioca con la prospettiva.
Di solito le fotografie rappresentano scene del mondo reale, ma la fotografia astratta va nella direzione opposta.
«Chiedo sempre ai principianti di pensare al mondo in modo meno concreto. Bisogna esplorare cose nuove, pensare alla luce e all'ombra in modo diverso e considerare la forma e la ripetizione. Cerco di incoraggiarli a uscire dai sentieri battuti.»
Giocando con la prospettiva, infatti, si riesce a vedere il mondo da una nuova angolazione, trovando magari uno scatto che riesce a trasmettere qualcosa di unico.
Invece di catturare un’immagine still life da una prospettiva classica, prova punti di vista diversi a cui non avevi pensato prima. Prova a scattare una foto astratta riprendendo l’oggetto dall’alto o dal basso. Non avere timore di sperimentare con la prospettiva: allenerai il tuo occhio così da vedere oltre quello che hai di fronte.

2. Scopri la fotografia macro.
Un’ottima tecnica per scoprire una nuova prospettiva è quella di zoomare sui tuoi soggetti per produrre delle foto astratte.
“Giocando” con le proporzioni puoi valorizzare i dettagli di un oggetto:
«Molte persone usano obiettivi macro per questo tipo di fotografia, perché così riescono a semplificare il soggetto.»

3. Gioca con texture e luci.
Considera di valorizzare nelle tue foto gli effetti dati da texture e tonalità.
«Puoi trasformare la foto di un vecchio termosifone con la vernice scrostata in qualcos’altro che sposta l’accento sui pattern, il colore, la luce e la texture.»

La fotografia naturalistica, che cerca di catturare nuove prospettive degli oceani, del cielo o di una foresta, è ottima per sperimentare con diverse texture.
La fotografia area di un oceano, ad esempio, può diventare facilmente un’immagine astratta, poiché i colori e le forme delle onde si fondono insieme dando vita a panorami mozzafiato.
Inquadrandole nella giusta angolazione, anche le forme architettoniche di una fabbrica possono dar vita a texture particolari dai motivi geometrici, permettendoti di realizzare una foto astratta a tutti gli effetti.
A prescindere da ciò che scegli di ritrarre, prova a decontestualizzare il tuo soggetto concentrandoti sulla texture e sulla tonalità: solo così potrai creare un’eccellente fotografia astratta.

4. Fotografa oggetti in movimento.
Di solito le foto tradizionali vengono scattate con velocità dell’otturatore elevata per immortalare un singolo momento ben definito. Riducendo la velocità dell’otturatore sarai in grado di aggiungere del movimento alla tua immagine e, in questo modo, creare una fotografia astratta.
Usa una lunga esposizione, lasciando l’otturatore aperto più a lungo, per ottenere la sfocatura di un oggetto in movimento. Ad esempio, se tieni ferma la fotocamera inquadrando un’auto in movimento, questa apparirà sfocata e in moto mentre il resto dell’immagine sarà statico.
Ciò che otterrai sarà una striscia colorata che attraversa l’immagine, mentre gli altri oggetti resteranno riconoscibili.
Utilizza questa tecnica per creare foto in movimento di elementi dinamici come acqua, fumo o fuoco e crea una foto astratta lontana dalla realtà per come la conosciamo.

5. Utilizza le ombre.
Hai mai pensato di sfruttare sagome e ombre per creare una foto astratta? Particolari e molto spesso non decifrabili o poco chiari, questi espedienti decisamente low-cost ti permetteranno di inserire l’elemento di astrazione desiderato senza sforzo.
Usa le ombre per aggiungere forme e linee imprevedibili alla tua immagine astratta.

6. Includi dei riflessi.
Passeggiando ti sarà capitato sicuramente di imbatterti nei riflessi di edifici, alberi o oggetti vari su uno specchio d’acqua. Certamente ti sarà capitato anche di scorgere dei riflessi lontani all’orizzonte, camminando sull’asfalto rovente in estate.
Pensa a come puoi sfruttare questi effetti per ideare la tua fotografia astratta. Uno scatto realizzato immortalando un laghetto o anche solo una pozzanghera potrà dare alla tua immagine un tono impressionista, aiutandoti a creare un’astrazione da un oggetto reale.

7. Metti fuori fuoco gli oggetti.
Lasciati ispirare dall’arte impressionista e sfrutta il fuori fuoco per creare foto astratte. Attenzione alla profondità di campo, che non deve essere troppo corta, e considera un’apertura almeno tra i valori f/4 e f/5,6.
Quando avrai individuato l’oggetto, sperimenta il fuori fuoco per ottenere il risultato che hai immaginato.

8. Usa il bianco e nero.
L’assenza di colori può creare quell’astrazione che non si percepirebbe se l’immagine fosse colorata. Per scattare una foto astratta puoi sfruttare le combinazioni di grigio e le sue tonalità per nascondere la realtà.

9. Trasmetti emozioni.
La fotografia astratta non significa immortalare oggetti e sfumature privi di senso. Prova a utilizzare tonalità scure, sul blu o viola, per rappresentare la tristezza, oppure tonalità chiare come il giallo o verde per trasmettere un senso di felicità. Una foto astratta è ricca di significato e racconta molto sia dello stato d’animo del fotografo sia delle emozioni che l’ambiente trasmette.

10. Sfrutta la post-elaborazione.
Non è detto che la fotografia astratta emerga solo davanti all’obiettivo di una fotocamera. Infatti, puoi creare un’immagine astratta anche in fase di post-produzione grazie ad Adobe Photoshop.
«Cambia la saturazione delle immagini. Scopri le diverse operazioni possibili giocando con le curve RGB dell'immagine e modifica il contrasto.»

I generi della fotografia astratta.
Esistono molti generi di fotografia astratta, ecco quindi un elenco che ti aiuterà ad avere una panoramica:
- Fotografia completamente astratta – non consente di riconoscere alcun elemento della realtà.
- Fotografia parzialmente astratta – non completamente isolata dalla realtà.
- Fotografia astratta minimalista – sfrutta pochi elementi per ottenere l’astrazione.
- Fotografia metafisica – trascende la fisicità per andare oltre al reale e al quotidiano.
- Macrofotografia astratta – rende gli oggetti irriconoscibili grazie all’utilizzo del macro.
- Fotodinamismo – foto astratte illusorie inserendo il movimento e la sfocatura.
- Panning – sfuma lo sfondo invece di muovere l’oggetto.
- Fotografia astratta e cubismo – insieme per ottenere illusioni surreali sfruttando la sfocatura e la geometria.
FAQ: Domande frequenti.
Quali sono i generi della fotografia astratta.
I generi della fotografia astratta sono molteplici, si passa dalla completa astrazione a quella parziale. È possibile, inoltre, creare un’immagine astratta unendo diverse tecniche come quella minimalista o il cubismo, ma anche il fotodinamismo e il panning.
Chi sono i maggiori esponenti della fotografia astratta?
Uno dei maggiori esperti di fotografia astratta oggi è il finlandese Ola Kolehmainen, che prende ispirazione dall’architettura come base per le sue immagini astratte. Oltre a lui, Andrew S. Gray sfrutta dipinti e panorami per scattare foto astratte. Tra gli italiani invece Franco Fontana realizza opere strettamente legate all’uso del colore per esprimere emozioni e sensazioni.
Le fotografie astratte hanno un significato?
Se le foto non avessero alcun significato non riuscirebbero a trasmettere emozioni e sensazioni che sono alla base dell’arte. Soprattutto per le fotografie astratte è necessario che queste trasmettano felicità, ansia o tristezza: il loro fine ultimo è suscitare emozioni.
Collaboratori
Tina Tryforos, professoressa e fotografa americana che esplora con le sue foto le complicate relazioni che le persone hanno con il mondo naturale.
John Spannos, fotografo e creatore di contenuti, molto conosciuto per il suo lavoro pubblicitario.